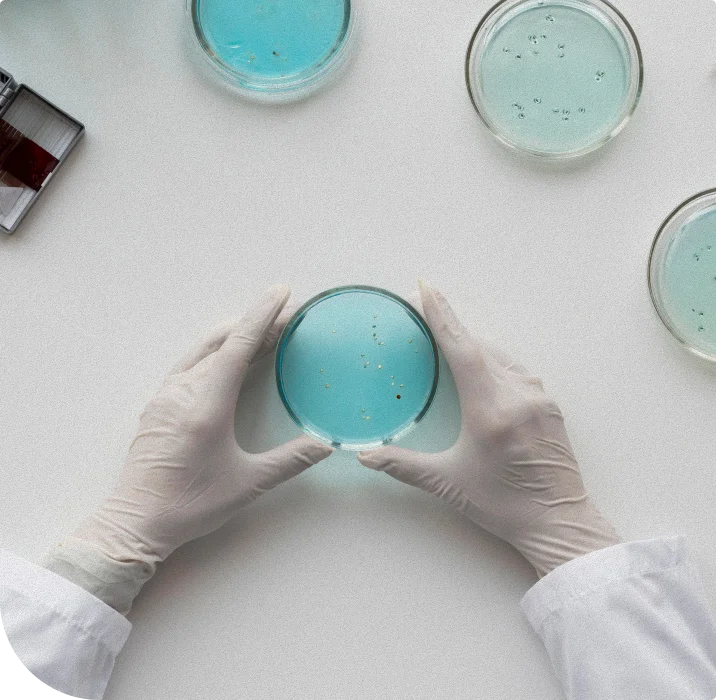

Ciencia aplicada para resolver retos técnicos y estratégicos de alto impacto.
Acompañamos a emprendedores, empresas e instituciones que enfrentan desafíos complejos en productos, procesos y toma de decisiones, integrando ciencia, tecnología e inteligencia empresarial.
Ciencia aplicada para resolver retos técnicos y estratégicos de alto impacto.
Acompañamos a emprendedores, empresas e instituciones que enfrentan desafíos complejos en productos, procesos y toma de decisiones, integrando ciencia, tecnología e inteligencia empresarial.
Ciencia aplicada para resolver retos técnicos y estratégicos de alto impacto.
Acompañamos a emprendedores, empresas e instituciones que enfrentan desafíos complejos en productos, procesos y toma de decisiones, integrando ciencia, tecnología e inteligencia empresarial.
Solucionamos lo que otros no logran resolver.
Aplicamos conocimiento científico con enfoque práctico para descifrar retos críticos.
Decisiones informadas, no intuitivas.
Convertimos datos, evidencia técnica y experiencia en decisiones estratégicas sólidas.
Acompañamiento de alto nivel.
Trabajamos de la mano con Dirección General, Consejos y equipos técnicos.
SECTORES ATENDIDOS: Electromovilidad | Agroindustria | Salud | Alimentos y Bebidas | Otros

QUIÉNES SOMOS
Una empresa mexicana especializada en ciencia, tecnología e innovación aplicada.
Gaia Plus Technologies es una empresa 100% mexicana, con sede en Guadalajara, Jalisco, dedicada a la Ciencia, la Tecnología y la Innovación. Acompañamos a organizaciones que requieren soluciones técnicas profundas, confiables y ejecutables en entornos complejos y altamente regulados.
SERVICIOS
Servicios técnicos especializados
Cuando el problema es técnico, la solución debe ser científica.
Estrategia e inteligencia empresarial
Ciencia y experiencia al servicio de la toma de decisiones.
Capacidades de digitalización
Integración armónica de la digitalización y la inteligencia artificial.

CAPACIDADES E INFAESTRUCTURA
Capacidad técnica respaldada por infraestructura y alianzas estratégicas.
Contamos con acceso a infraestructura analítica y tecnológica de primer nivel a través de alianzas con universidades, centros de investigación y laboratorios especializados que amplían nuestro alcance técnico.
- Análisis químico, bioquímico y microbiológico
- Servicios analíticos certificados
- Desarrollo y validación de metodologías
nuestro enfoque
Rigor científico, visión estratégica y orientación a resultados.
Cada proyecto se ejecuta bajo principios de confidencialidad, trazabilidad técnica y responsabilidad profesional, asegurando soluciones viables, reproducibles y alineadas a los objetivos del cliente.

NUESTRO EQUIPO
Un equipo multidisciplinario con experiencia real en la industria.
Nuestro equipo está integrado por personas científicas y tecnólogas con más de 20 años de experiencia aplicando conocimiento en ambientes reales.
CONTACTO
Cuéntanos tu desafío
Si enfrentas un desafío técnico, estratégico o de innovación, estamos listos para acompañarte.